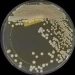
ABD alarmda: İlaca dirençli mantar hastalığı yayılıyor

Seçimler yaklaşırken parti başkanları hakkında araştırmalar yapılıyor. Milli Yol Partisi Genel Lideri Remzi Çayır’ın kim olduğu merak ediliyor. Pekala, Ulusal Yol Partisi Genel Lideri Remzi Çayır kimdir? Remzi Çayır nereli, kaç yaşında? İşte detaylar…
REMZİ ÇAYIR KİMDİR?
Remzi Çayır, 1959 yılında Kahramanmaraş’ın Abbaslar köyünde doğdu. 12 Eylül 1980 darbesi öncesi Ankara Üniversitesi Fen Fakültesi’nde öğrenciyken ülkücü faaliyetleri nedeniyle 1979 yılında tutuklanarak cezaevine girdi. Cezaevinde Anadolu Üniversitesi İktisat Fakültesi‘ni bitirdi. 1991 yılında cezaevinden çıktı.
Büyük Birlik Partisi (BBP) Kurucu Genel Lideri Muhsin Yazıcıoğlu ile birlikte Milliyetçi Çalışma Partisi‘nden istifa edenlerin kurduğu BBP’nin kuruluş sürecinde yer aldı. 28 Şubat davasına müdahil oldu. 2014 yılı mahallî seçimlerinde BBP’den Ankara Büyükşehir Belediye Lider adayı oldu. 25 yıl BBP Genel Lider Yardımcılığı ve Merkez Karar Yürütme Heyeti Üyeliği misyonunu yaptıktan sonra partiden ayrıldı.
BBP’den ayrıldıktan kısa bir mühlet sonra silahlı suikast teşebbüsüne uğradı. Bir müddet Milli Yol Hareketi sözcülüğünü yaptıktan sonra Milli Yol Partisi‘nin kurucusu ve birinci genel lideri oldu.
REMZİ ÇAYIR ÖZEL YAŞAMI
Remzi Çayır, evli ve bir çocuk babasıdır.
REMZİ ÇAYIR KİTAPLARI
- Koğuş Türkiye Koğuş Dünya
- Onlar Diridirler
- Zerafetin Fal Çiçekleri
- Adım Yeşil
- Mamak Mapushanesi
- Gel Dedin Geldim İşte
- Diktatörü Gördüm
- İşkenceyi Yaşadım
- Alperenlerin Davası